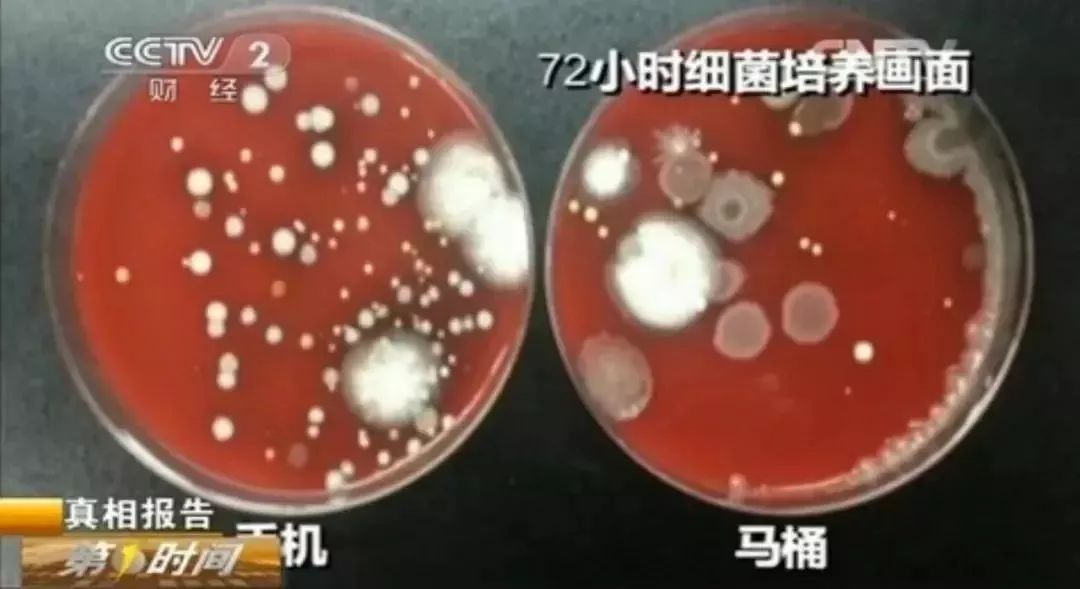
经常清洁可以消除大量的细菌,细菌和脏东西特别不容易清洗

意想不到,手机上的细菌可能比马桶还多。英国曾经有一项研究显示,英国人使用的手机中有近四分之一存在健康威胁,平均一部手机携带的细菌量是厕所马桶冲水把手细菌含量的18倍之多。
想想好像很夸张,我们一起来看看这到底是怎么回事!
手机与马桶,谁更脏?
现在几乎是人手一台手机,手机也成为了我们的“贴身物品”。不过,这个“贴身物品”确实存在着很多细菌,可能比马桶还脏。
央视新闻曾做过这样的两组实验:分别将用过3年和1年的、且都未清洁过的手机与某商场的马桶圈作对比。
将检测样本进行36小时的恒温培养后,结果显示,用了3年的手机所含的菌落总数比马桶圈多;相反,用过1年的手机,其菌落总数比马桶圈少。也就是说,手机分分钟有可能比马桶脏。

但是,有专家表示,这样的对比不能一概而论,细菌的多少要根据个人卫生而定!除了个人卫生,结果也可能与选取检测的部位不同有关系,如选取的是家用马桶还是公共卫生间里的马桶、是马桶把手还是马桶圈等都有可能影响检测结果。
无论如何,注意个人卫生,及时清洁手机、马桶才是最重要的。
及时清洁手机,避免细菌入口
事实上,我们的手机用久了,自然会沾染上很多“脏东西”,除了灰尘之外,还可能有大肠杆菌、沙门氏菌、诺如病毒等细菌。
手机也是目前疾病的传染载体,当手接触到结膜炎、病毒性流感等病原体后,又频繁接触手机,这些病原体会通过呼吸道、口腔、结膜等传播,导致人体感染这些致病菌。

不过,并非每个人的手机都有致病菌,南京市第一医院感染科陶臻主任提醒:大多数情况下,手机上的细菌几乎是无害的,除了部分职业工作者的手机可能会有致病菌,特别是医护工作者需要特别注意清洁手机。
所以,做好手机清洁十分重要。大家有必要帮自己的手机认认真真地“洗一次澡”!

清洁方法
手机的表面附有涂层,使用微湿的无绒软布(眼镜布、湿巾)擦拭即可;如果有清洗不掉的污迹,可以加上温肥皂水一起擦拭;手机壳也要用肥皂水清洁,注意用无绒软布仔细擦拭手机壳与手机夹缝之间的灰尘。
小健建议,最好不要用酒精或含有酒精的清洁剂擦拭手机,因为酒精有可能会损伤手机表面的涂层。
还有,最好不要一边吃东西一边玩手机,记住要勤洗手;把手机放在专用手机套内,使其与其他物品,如钱包、钥匙、钱等隔离开。
这3种生活常见物品,也比马桶脏
在日常的生活中,说起家里的“脏东西”,除了马桶和手机,还有我们的一些生活用品,如砧板、牙刷和洗衣机。根据国内外的相关研究表明,这些生活用品比马桶更脏。
1
砧板

砧板干不干净,与我们的健康息息相关。如果砧板洗不干净,一不小心就滋生百万病菌。
美国哈佛大学的一组研究数据显示:日常家用木质、竹制的砧板,细菌含量高达2.6万个/m²,使用了3个月以上的砧板,每平方里面含有2亿个细菌!据相关的测定,在砧板上每平方厘米有200万个葡萄球菌,几万个大肠杆菌,是马桶的2倍。
大多数家庭长期不更换砧板,而且将生、熟食放在同一块砧板上切。这样一来,砧板会产生刀痕、掉渣、清洁不彻底等问题,很容易造成交叉感染、滋生细菌。

清洁方法
将小苏打均匀洒在砧板上,喷洒少量水后用刷子刷洗干净,然后将砧板上的小苏打残留物冲刷干净,用干抹布擦拭后放在通风处晾干即可。如果砧板发霉,可以将其用泡淘米水浸泡。
小贴士:新砧板可以先用浓盐水浸泡1-2天后再使用,盐能起消毒杀菌的作用。
2
牙刷

牙刷使用完后,刷毛上会残留牙膏、食物残渣等杂质,若不搓洗干净,容易滋生病菌。美国牙科专家盖瑞•库拉托拉博士表示,牙刷可能会成为细菌、病毒、真菌和霉菌的温床。
有实验发现,在使用过 2 周的牙刷中,发现了 73 万个细菌数,是抹布水的 9 倍、马桶水的 80 倍。
而使用超过3个月后,牙刷的刷毛充斥着大量细菌,细菌可通过口腔破损处或食道进入人体,引起疾病的发生。

清洁方法
选用温肥皂水清洗牙刷后,用干净的布拭擦牙刷,并将其放置在通风处晾干。清洁干净的牙刷应刷头朝上放置,注意刷头不要接触别人的牙刷,避免交叉传染。
小贴士:及时更换牙刷是保证口腔卫生的关键,牙刷尽量每月换一次,电动牙刷建议3-4个月换一个刷头。
3
洗衣机

别看洗衣机的表皮干干净净,其实污垢和细菌都藏在外筒里,比下水道还脏。如果长期不清洁洗衣机的话,洗衣机会长满螨虫,可能会依附在转筒的衣服上。
疾控中心的专家对 128 台用了上半年的洗衣机,做了细菌污染抽样调查,结果发现家用洗衣机细菌超标率高达 81.3%。
火箭军总医院皮肤科主任医师曾指出,洗衣机污垢霉菌会引起脚廯、手廯、霉菌性阴道炎、慢性*麻疹荨**等。

清洁方法
选用有除菌、除垢功能的洗衣机专用清洁剂,将洗衣机槽清洁剂直接全部倒入洗衣筒内,按正常洗涤模式运行洗衣,运行约20分钟后停止,待浸泡2小时后继续运行洗衣机30分钟,最后排水、晾干即可。部分洗衣机有自洁功能的,可以将清洁剂倒入,洗衣机自动清洗即可。
小贴士:如果是长期未清洁过的洗衣机,污垢会比较多,建议选择用40℃的温水清洗。
安全卫生要注意
回去好好试试吧